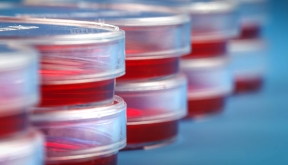
hematologia-coi-carrusel-enfermedades-hematooncologia
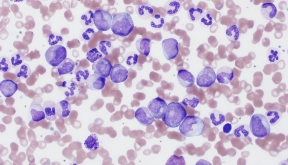
hematologia-coi-carrusel-mieloproliferativas
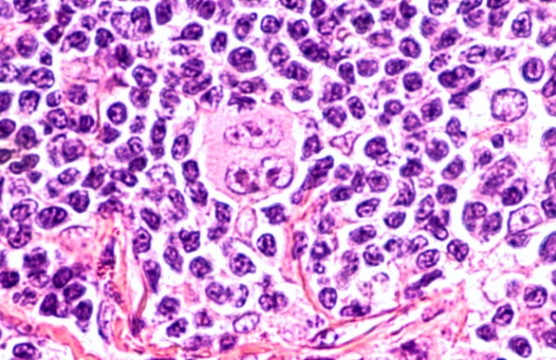
hematologia-coi-linfoma-img1

Nuestro equipo de Hematólogos atiende a más de 700 pacientes anualmente
División de Hematología
Brinda atención personalizada e integral a más 700 pacientes anuales con trastornos de la sangre
La hematología es la rama de la medicina que se encarga de estudiar los componentes de la sangre, los órganos linfoides y la médula ósea.
Nuestro equipo de especialistas en hematología se encarga del estudio, diagnóstico y tratamiento de las enfermedades relacionadas con la sangre, el sistema linfoide y la médula ósea.

Si tú, un familiar o amigo tienen un padecimiento de la sangre, en Centro Oncológico Internacional los podemos ayudar.

La hematología benigna se ocupa del estudio de las enfermedades no oncológicas de la sangre, que generalmente afectan la cantidad o la producción de células sanguíneas, así como las alteraciones de la coagulación.
Los principales trastornos estudiados en hematología benigna son: anemia, neutropenia, trombocitopenia, trombosis y hemorragia
El estudio utilizado para determinar si un paciente tiene anemia es la biometría hemática que proporciona información sobre la cantidad de hemoglobina, glóbulos rojos, tamaño y color de los mismos.
Junto con una historia clínica detallada, exploración física y otros estudios de laboratorio complementarios, esto nos permite determinar la causa de la anemia. En situaciones especiales, puede ser necesario realizar un estudio llamado frotis sanguíneo, que permite examinar las células sanguíneas bajo el microscopio y proporciona información sobre la forma y alteraciones de los glóbulos rojos.


El tratamiento de la anemia depende de su causa, ya que la anemia en sí no es una enfermedad, sino el resultado de otra patología. Es necesario corregir la enfermedad subyacente para proporcionar un tratamiento adecuado.
El uso de vitaminas o minerales (ácido fólico, complejo B, hierro, cobre) sin prescripción médica puede aumentar el riesgo de padecer otras enfermedades. Siempre es importante tratar la enfermedad de base, como la gastritis, los divertículos o los miomas, para abordar adecuadamente la anemia.

¿Qué es la trombocitopenia?
Es la disminución anormal de la cantidad de plaquetas por debajo del límite normal (150,000).
¿Qué son las plaquetas?
Las plaquetas son pequeños fragmentos de células más grandes (trombocitos) que participan en la coagulación y en la reparación de heridas. Su disminución puede provocar hemorragias que no se detienen con facilidad, como sangrado de las encías, nariz o menstruación abundante.

El diagnóstico de la trombocitopenia se realiza mediante el recuento de plaquetas en la biometría hemática. Es importante verificar el recuento de plaquetas de forma manual, lo cual es realizado por un hematólogo al observar una gota de sangre bajo el microscopio. A diferencia de la anemia, la trombocitopenia puede ser primaria (sin causa aparente) o secundaria, aunque no siempre.



Es un tipo de cáncer de la sangre en el que las células de defensa (leucocitos) se producen de manera anormal, ya sea en cantidad o en maduración. Existen muchos tipos de leucemia.
La leucemia implica una producción anormal de células formadoras de defensas en la médula ósea. Cuando se producen grandes cantidades de células sanguíneas (maduras o inmaduras) que no cumplen su función habitual, pueden aparecer infecciones recurrentes, hemorragias y/o formación de coágulos.

Se realizan estudios de sangre, como la biometría hemática o el frotis de sangre periférica, y un procedimiento llamado aspirado de médula ósea. Este último consiste en extraer un poco de médula ósea (conocida coloquialmente como tuétano) del hueso de la cadera para su análisis, estudio especializado y diagnóstico.




El tratamiento de la leucemia puede incluir quimioterapia, inmunoterapia y terapia dirigida que pueden administrarse por vía oral, intravenosa o intratecal.
Es un tipo de cáncer que afecta a los linfocitos, células especializadas en la defensa del cuerpo, y se localiza principalmente en los ganglios linfáticos. Hay dos tipos de linfoma: el linfoma de Hodgkin y el linfoma no Hodgkin.
El linfoma se caracteriza por la producción excesiva y anormal de linfocitos, que se acumulan en los ganglios linfáticos de diferentes partes del cuerpo.
El diagnóstico del linfoma implica la realización de diversos estudios, como análisis de sangre para detectar anemia, aumento de linfocitos o alteraciones en la función hepática. Sin embargo, el diagnóstico definitivo se realiza mediante una biopsia de un ganglio linfático afectado, que debe ser revisada preferentemente por un hematopatólogo (especialista en patología hematológica)
Además, se puede emplear una tomografía con contraste intravenoso o, idealmente, una tomografía por emisión de positrones (PET) para evaluar adecuadamente la etapa de la enfermedad.




El tratamiento del linfoma puede incluir quimioterapia, inmunoterapia y terapia dirigida. Estas terapias pueden administrarse por vía oral o intravenosa, según el caso.
El mieloma múltiple es un tipo de cáncer que afecta a las células plasmáticas, un tipo de linfocitos especializados en la producción de anticuerpos o inmunoglobulinas. Se caracteriza por la producción excesiva y anormal de anticuerpos
En el mieloma múltiple, se produce de manera descontrolada un exceso de anticuerpos que pueden afectar los huesos, los riñones y otros órganos del cuerpo. Los síntomas principales son anemia, elevación de calcio en sangre, insuficiencia renal y destrucción ósea, principalmente en la columna vertebral (fracturas patológicas).

Para confirmar el diagnóstico de mieloma múltiple, se requiere determinar si una cadena de globulinas es “monoclonal” o “policlonal”. Además, se realiza un estudio de la médula ósea mediante una aspiración de médula ósea.




El tratamiento del mieloma múltiple puede incluir quimioterapia, inmunoterapia y terapia dirigida. Al igual que en el linfoma, estas terapias pueden administrarse por vía oral o intravenosa. En algunos casos, puede ser necesario un trasplante de médula ósea.
El aspirado de médula ósea es un procedimiento diagnóstico que se realiza en la cadera (espina iliaca) o en el esternón. Consiste en la inserción de una aguja especial (aguja Jamshidi) después de la aplicación de anestesia local.
Se extrae una muestra de médula ósea, también conocida como tuétano, para su estudio en el microscopio y mediante análisis especializados en sangre. Además, durante este procedimiento se obtiene un pequeño fragmento de hueso que se envía a patología para complementar el diagnóstico.


para compartirte más información de cómo podemos ayudarte
*Campos obligatorios
Aviso de privacidad